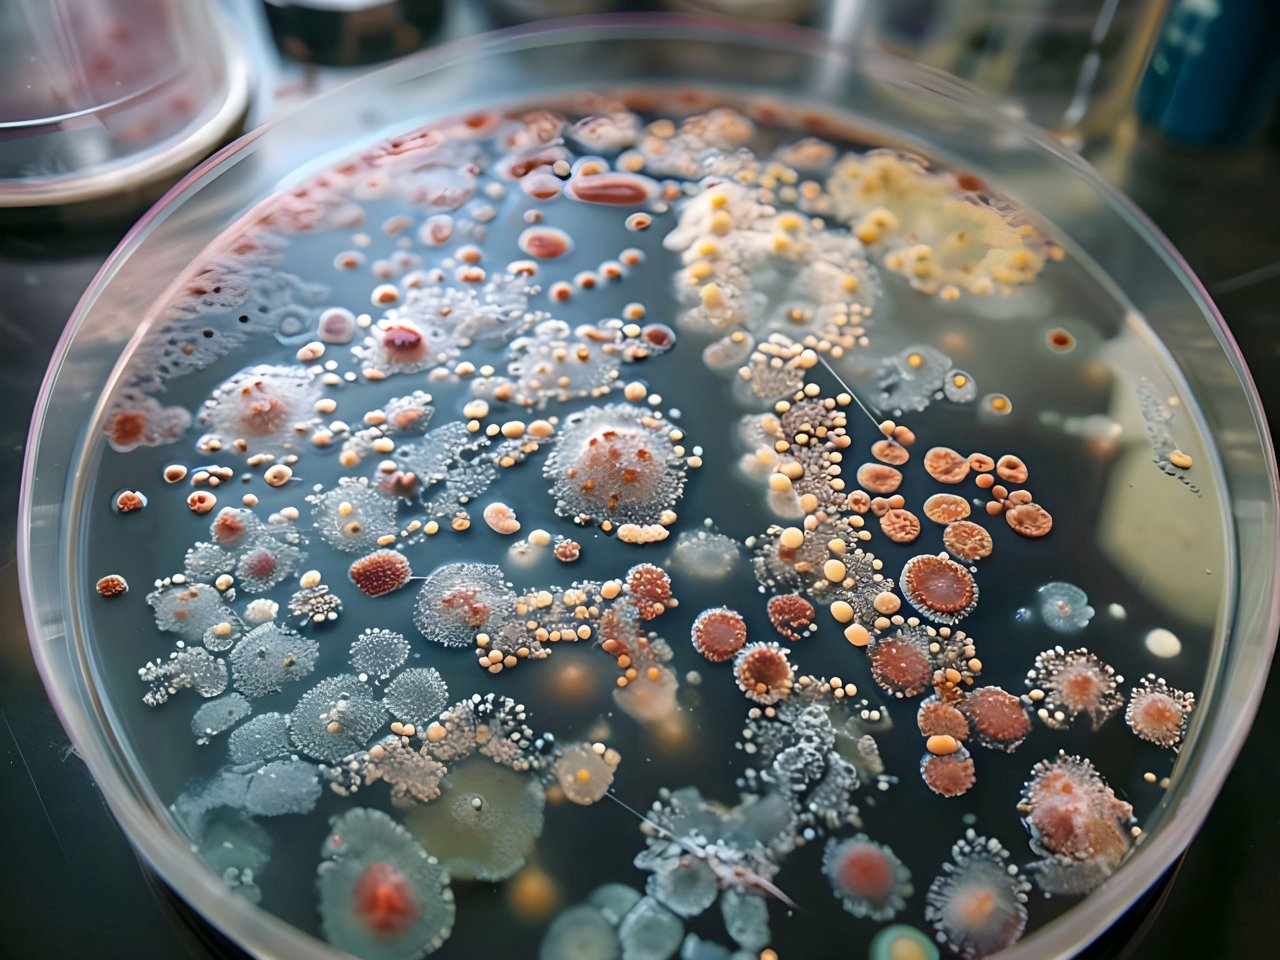
AdobeStock_951752719

Mögeltest
Gör det själv
Vi har tagit fram anpassade paket för mögeltester.
Där du som beställare placerar, genomför och rapporterar mätningen via vår vägledning genom hela processen.
Kort om mögeltester
Vad är mögel? Mögel utgör en mikrobiell organism som tillsammans med bakterier kan skapa besvär i inomhusmiljön. Detta kan vara förkylningssymptom, huvudvärk m.m.
Varför är det viktigt? Höga halter av mögel och bakterier i inomhusmiljön är skadligt och kan leda till exempelvis utvecklad Astma.
När och hur inträffar det? Tillväxt av mögel och bakterier kan ske dolt i byggnadsmaterial och är därmed svåra att upptäcka visuellt, oftast i kombination en med fukt- eller vattenskada.
Genom att mäta rumsluften så får du en indikation om det förekommer kritiska halter av mögel och/eller bakterier i rumsluften.
Några fördelar med mögeltester DIY tillsammans med oss
Spara pengar
Ett billigare sätt för dig att få mögeltest utförd med kvalificerad personal för vägledning.
Fri frakt
Transport av testpaket sker kostnadsfritt till angiven plats enligt beställningsformulär.
Säker leverans & betalning
Leverans av testpaket sker till anvisad plats och betalning sker först när leveransen är mottagen.
Ökad medvetenhet
Du får kunskap om potentiella inomhusmiljöproblem och hur du skall hantera dessa.
Miljövänlig
Testpaket postas till mätplatsen eller närmaste utlämningsställe enligt beställningsformulär.
Support & Rådgivning
Tillgänglig och kvalitativ kundsupport både under och efter provtagningsprocessen.
- Petriskål med odlingsmedium.
- Tydliga instruktioner anpassade till ert provtagningsobjekt.
- Rådgivning beträffande provtagningsresultat av sakkunnig.
Om provtagningstekniken
- Förberedelser: Innan testet påbörjas ska rummet ha stängda dörrar och fönster i minst 6 timmar för att säkerställa att inga yttre faktorer påverkar luftkvaliteten.
- Placering av petriskål: En petriskål med ett specialutvecklat odlingsmedium placeras på en plan yta i rummet. Detta medium ger en optimal yta för mögelsporer att fastna och växa på.
- Öppen exponering: Locket på petriskålen avlägsnas, vilket gör att mögelsporer från luften kan falla ner på odlingsmediet. Petriskålen lämnas öppen i rummet i 60 minuter.
- Tillslutning: Efter en timmes exponering sätts locket tillbaka på petriskålen för att stänga ute nya sporer och förhindra kontaminering.
- Förvaring: Petriskålen förvaras sedan på en mörk plats vid rumstemperatur (ca 20-25°C) i ungefär 4 dagar. Under denna period börjar eventuella mögelsporer som fastnat på mediet att gro och bilda kolonier.
- Kolonitillväxt: Mögelkolonier blir synliga som små fläckar på mediet. Varje fläck representerar en mögelkoloni, och det är dessa kolonier som senare räknas för att bedöma luftkvaliteten.
- Räkning av kolonier: Efter 4 dagar (eller i vissa fall upp till 5 dagar) öppnas petriskålen och antalet synliga mögelkolonier räknas. Storleken på kolonierna är inte viktig, utan det är antalet som avgör.
- Bedömning: Antalet kolonier jämförs med en bedömningsskala:
- 0–3 kolonier: Bra luftkvalitet.
- 4–6 kolonier: Ofta acceptabelt, men möjligen ett mindre problem.
- 7–10 kolonier: Hög mögelnivå som bör undersökas närmare.
- 11+ kolonier: För mycket mögel, åtgärd behövs.
Prisbild
Mögeltest
Paketet för mögeltest är en färskvara och skall monteras så fort som möjligt efter mottagandet.
Konsultation för utredning av eventuella avvikelser i analyssvar samt åtgärdsförslag sker enligt separat offert.
- Petriskål med odlingsmedium
- Tydliga instruktioner
- Skräddarsydda lösningar
- Kompletter service avseende utredning, åtgärd och uppföljning.
1250 kr / test- inkl. moms
